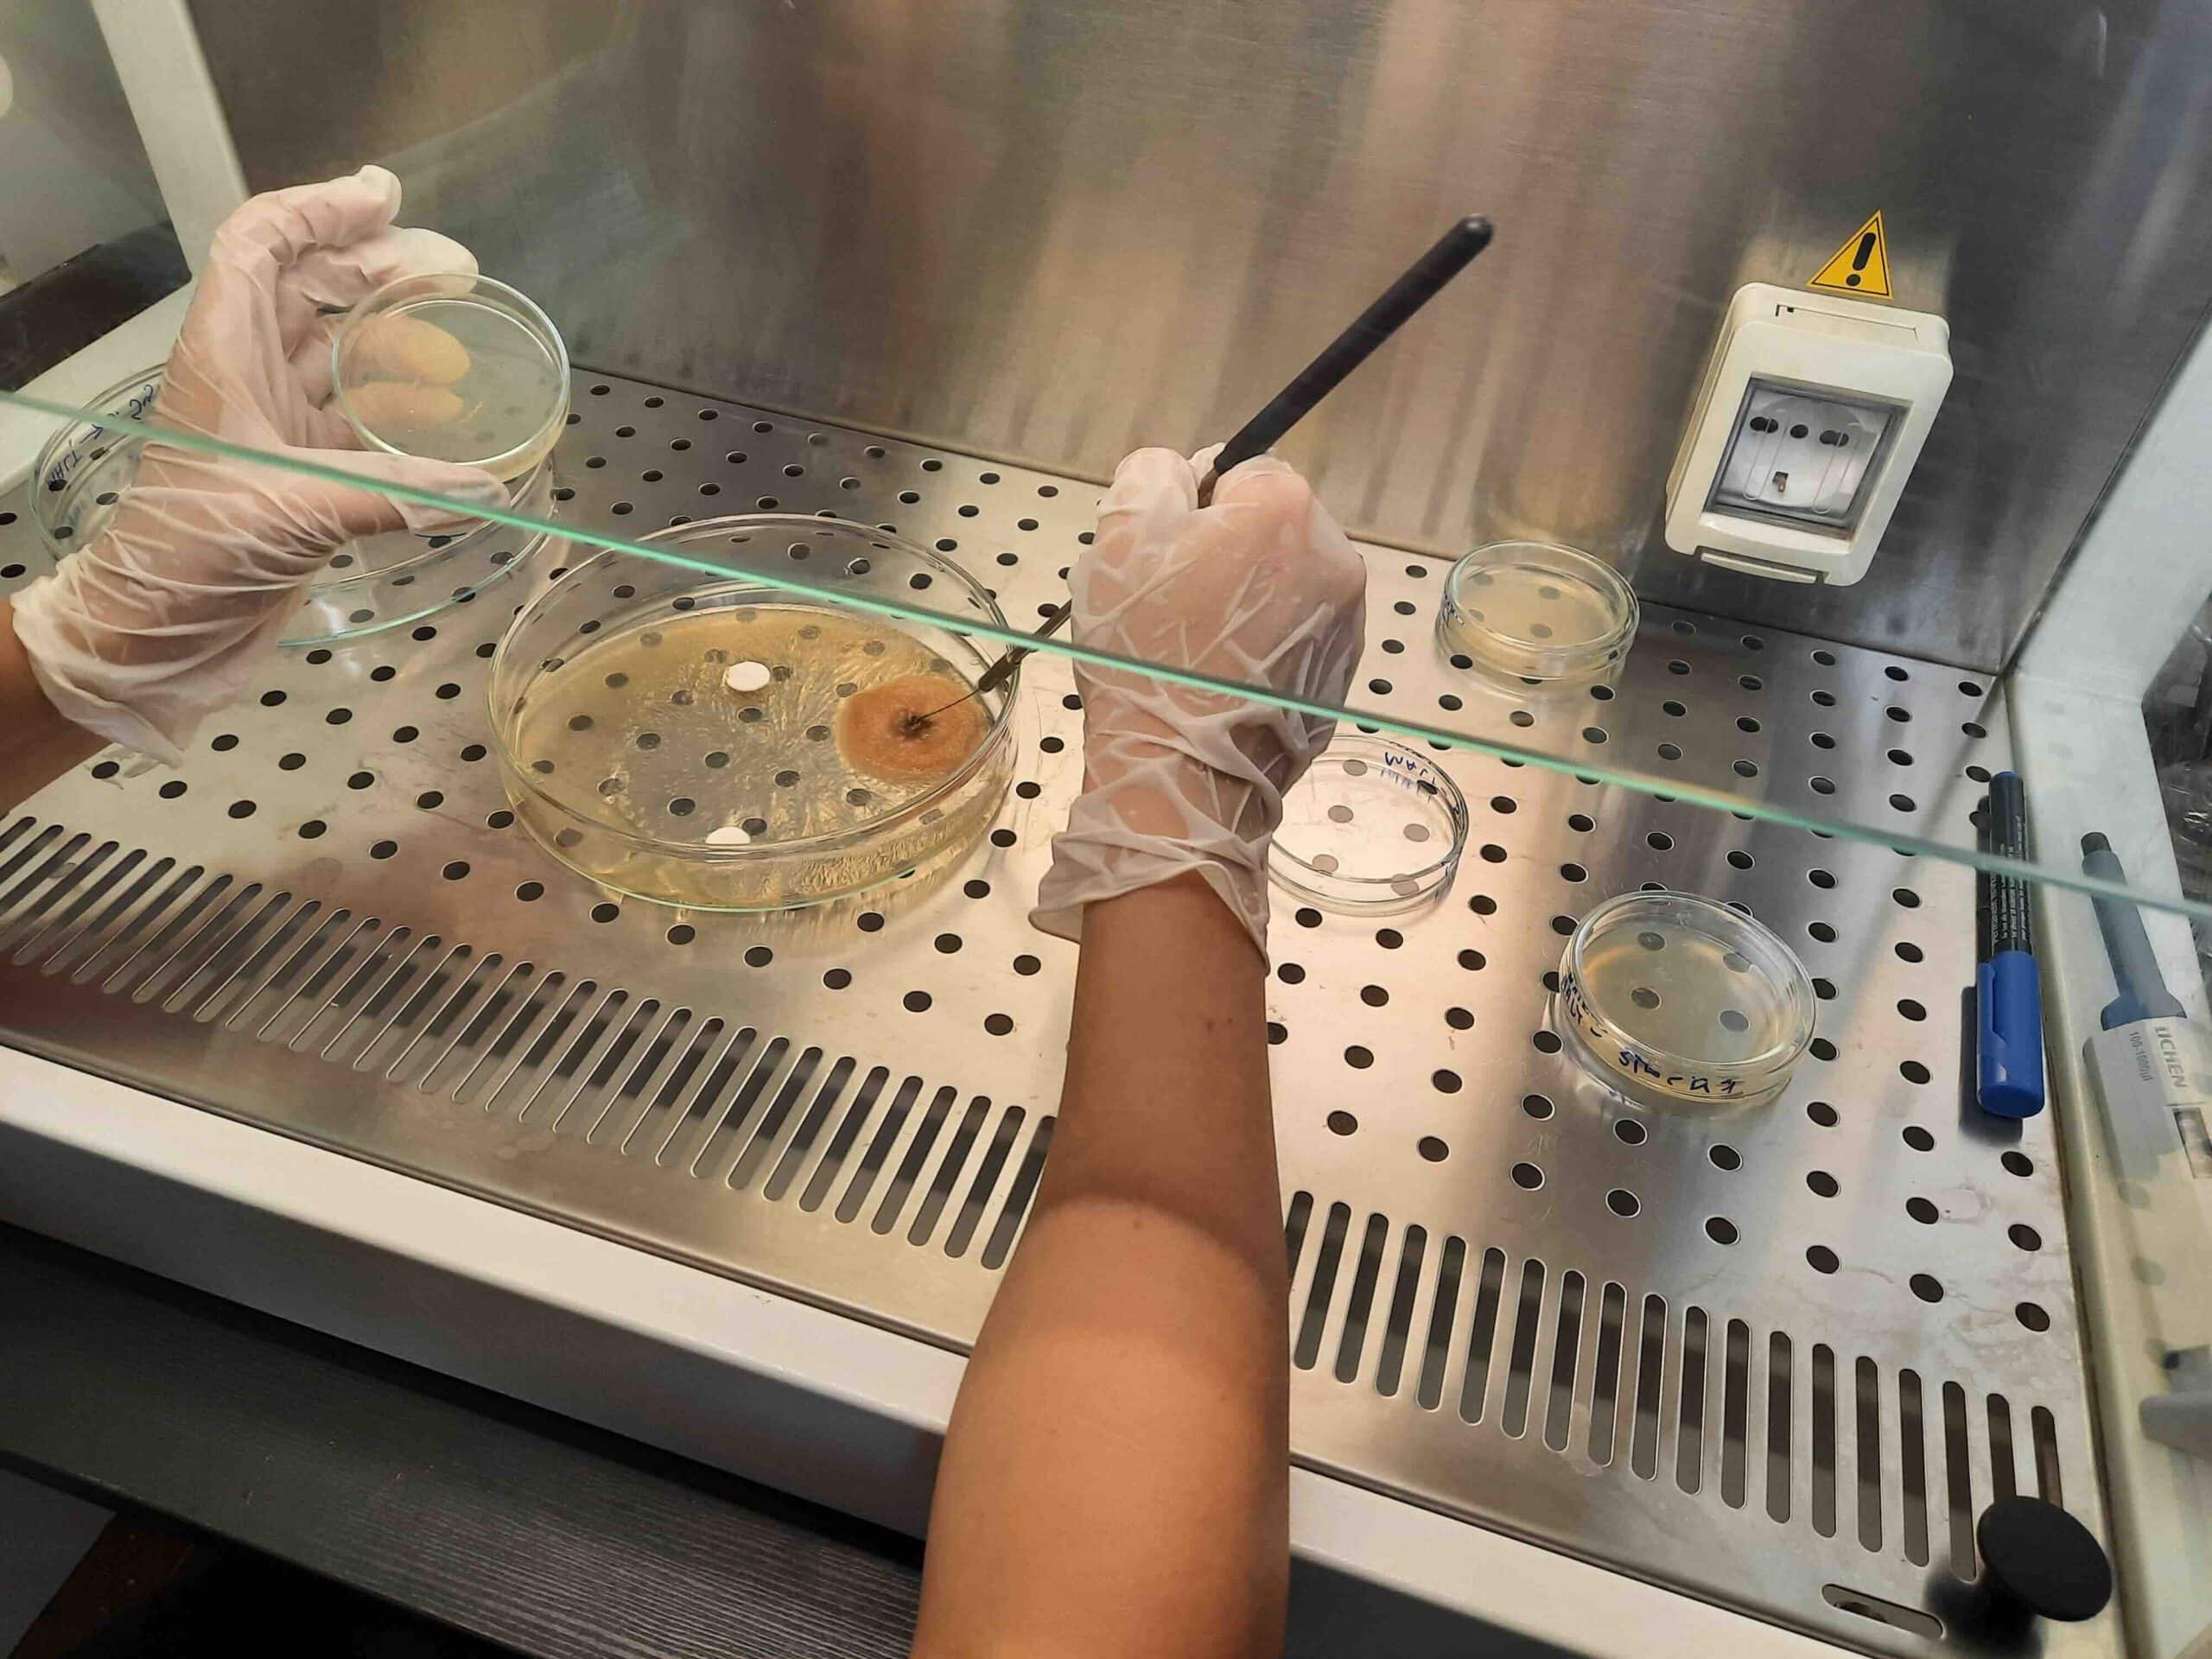

Signs of the Times
Artistic Research
Karolina Żyniewicz
While researching her project Signs of the Times artist and researcher Karolina Żyniewicz collected material traces and memories from the COVID–19 pandemic. In Spring 2021, she started collecting masks from the public areas of Berlin where she lived. In the next step of the process she began to meet people and hear about their memories of the COVID pandemic. Between 2022 and 2024, she organised 12 performative events to collect masks and memories, one of which took place during her Winter Residency at Art Laboratory Berlin between 10 January and 15 February 2022 (https://artlaboratory-berlin.org/events/signs-of-the-times/).
Every person she interviewed wore a fresh medical mask, and was asked one question: What do you think you will remember the most from the time of the COVID-19 pandemic, ten to twenty years from now? After collecting numerous interviews she transcribed and translated them by hand into a series of notebooks. She also collaborated with several laboratories (Institute of Genetics and Biotechnology in Warsaw, the Coalesce: Center for Biological Art in Buffalo, and the UR Institute in Zagreb) for genetic analysis of the microorganisms contained therein. “The goal was to culture microorganisms from the mask samples, identify them, and determine their genomic transcripts” explains the artist who was working in the lab for theses analyses herself. “Different methods were used in each laboratory, including bacterial Gram staining, phenotype analysis, and high-throughput sequencing. Protocols and photographic documentation form an integral part of the creative process.”
The performative installation of this exhibition, Signs of the Times, was developed by the artist during an EMAP residency at Kontejner in Zagreb, Croatia, in 2024. It’s purpose is to bring together human and nonhuman matter using new technologies, but requiring a human (the artist’s ) presence and action; here technology is an extension of the human (and nonhuman) but the human is also an extension of technology, an apt analogy of our times. During the exhibition the artist transcribes entries from her notebooks onto a tablet using a stylus, the handwritten results appear on a monitor on the wall. On another monitor the genetic transcript of microbial material from one of the masks appears letter by letter, line by line.
“The work is dedicated to remembering and forgetting, appearing, and disappearing,” Karolina Żyniewicz notes about Sign of the Times, “resisting the passage of time, and confronting the imperfections of human memory.”
During the exhibition opening hours (Thu – Sun, 2 – 6 pm) at Art Laboratory Berlin, Żyniewicz will perform her transcription from Thursdays to Saturdays, while being present Sundays to talk to visitors, and if they wish, lead further interviews that may contribute to future iterations of this research project.
Karolina Żyniewicz (PL/DE) is a Berlin-based artist&researcher&educator, a liminal being, existing and performing between various contexts and disciplines. She is a graduate of the Faculty of Visual Arts of the Strzemiński Academy of Fine Arts in Łódź and holds PhD in cultural sciences (obtained in the transdisciplinary program Nature-Culture at Artes Liberales Faculty, University of Warsaw). While executing art&research projects based mainly on biotechnology and medicine, she also conducts ethnographic and autoethnographic observations. In her work, she underlines the epistemic and didactic dimensions of art. In 2016–2018, she cooperated with the education departments of the Museum of Modern Art in Warsaw and the Zachęta National Gallery of Art, running workshops and museum lessons for regular audiences and with accessibility for visually impaired and deaf visitors. She uses these educational experiences in her own liminal practice. The topics of her work are often related to broadly understood life and death and their social and biological dimensions. That is why she is a member of the Institute of the Good Death in Warsaw. Her work is strongly process-oriented, so she often participates in residencies, like the European Media Art Platform (EMAP) at Kontejner Zagreb or Coalesce in Buffalo, NY, and group projects, like Stretching Senses School by Humboldt Cluster of Excellence Matters of Activity. She exhibited internationally, for instance, at Kunstquartier Bethanien in Berlin, Kontejner Zagreb, or The Center of Contemporary Art Łaźnia in Gdańsk, Poland. Additionally, she is an associate reviewer of the Technoetic Arts journal. In 2026 she published her first book titled The Body as Matter of Art and Science. Autoethnography of transmattering.
Press Feedback
KAROLINA ŻYNIEWICZ, art as a way to perceive the world, in CLOT Magazine London by Rae (Mee-Jin) Tilly (19 April 2026)